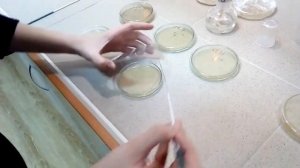
Сириус Февральская естественнонаучная программа - Бухарина Виктория

3:55
3:55
2025-12-07 17:32

 5:29
5:29

 5:29
5:29
2025-12-19 14:15

 5:47
5:47
5:47
5:47
2023-12-06 16:32

 8:49
8:49

 8:49
8:49
2025-12-21 03:33

 2:17:16
2:17:16

 2:17:16
2:17:16
2025-12-21 21:00

 1:57:17
1:57:17

 1:57:17
1:57:17
2025-12-20 21:00

 3:10:29
3:10:29

 3:10:29
3:10:29
2025-12-20 12:46

 1:51:06
1:51:06

 1:51:06
1:51:06
2025-12-19 21:20

 1:35:29
1:35:29

 1:35:29
1:35:29
2025-12-21 19:00

 26:12
26:12

 26:12
26:12
2025-12-21 18:36

 1:58:59
1:58:59

 1:58:59
1:58:59
2025-12-20 23:40

 3:12:39
3:12:39

 3:12:39
3:12:39
2023-12-21 11:54

 31:06
31:06

 31:06
31:06
2025-12-21 18:01

 1:29:13
1:29:13

 1:29:13
1:29:13
2025-12-18 16:00

 2:11:45
2:11:45

 2:11:45
2:11:45
2025-12-21 16:19

 2:40:56
2:40:56

 2:40:56
2:40:56
2023-09-10 18:55

 1:02:28
1:02:28

 1:02:28
1:02:28
2025-12-17 16:25

 1:23:45
1:23:45
![Фати Царикаева - Обманула (Премьера клипа 2025)]() 3:12
3:12
![Ахрорбек Хурсаналиев - Йигитнинг гами (Премьера клипа 2025)]() 6:09
6:09
![Шавкат Зулфикор - Узга юртда танам колиб кетмасин (Премьера клипа 2025)]() 6:27
6:27
![Султан Лагучев - Цок Цок (Премьера клипа 2025)]() 2:29
2:29
![Рухсора Отажонова - Бахтлимисан (Премьера клипа 2025)]() 3:04
3:04
![DJ Serzh - Танцуем грустно (Премьера клипа 2025)]() 3:36
3:36
![Сергей Сухачёв - Королева снежная (Премьера клипа 2025)]() 3:22
3:22
![MILEN - Шёпотом (Премьера 2025)]() 4:45
4:45
![Нодирбек Шомирзаев - Жон дейман жоним (Премьера клипа 2025)]() 3:05
3:05
![Анастасия Сотникова, Аделон - В пустом кафе (Премьера клипа 2025)]() 2:59
2:59
![Zemfira Ararat - Отпусти меня (Премьера клипа 2025)]() 3:45
3:45
![Бекзод Хаккиев - Ёр-ёр (Премьера клипа 2025)]() 4:10
4:10
![Рейсан Магомедкеримов - Девочка-зима (Премьера клипа 2025)]() 2:52
2:52
![Игорь Балан - Февраль (Премьера 2025)]() 2:53
2:53
![Пепел Слов - Пустота (Премьера клипа 2025)]() 2:55
2:55
![Тахмина Умалатова - Не тая (Премьера клипа 2025)]() 2:53
2:53
![Вусал Мирзаев - Без тебя я не могу (Премьера клипа 2025)]() 2:31
2:31
![Жасурбек Мавлонов - Дилором (Премьера клипа 2025)]() 4:25
4:25
![Наталья Влади - Гуляй от души (Премьера клипа 2025)]() 2:50
2:50
![Cvetocek7 - Поцелуй (Премьера клипа 2025)]() 2:13
2:13
![Мерв | Merv (2025)]() 1:46:56
1:46:56
![Безжалостная | Stone Cold Fox (2025)]() 1:25:31
1:25:31
![Сожалею о тебе | Regretting You (2025)]() 1:55:53
1:55:53
![Дом из динамита | A House of Dynamite (2025)]() 1:55:08
1:55:08
![Свинтусы | The Twits (2025)]() 1:42:50
1:42:50
![Хищник | Predator (1987) (Гоблин)]() 1:46:40
1:46:40
![Терминатор 2: Судный день | Terminator 2: Judgment Day (1991) (Гоблин)]() 2:36:13
2:36:13
![Рука, качающая колыбель | The Hand That Rocks the Cradle (2025)]() 1:44:57
1:44:57
![Протокол выхода | Exit Protocol (2025)]() 1:24:45
1:24:45
![Хищник: Планета смерти | Predator: Badlands (2025)]() 1:47:25
1:47:25
![Мой тайный Санта | My Secret Santa (2025)]() 1:32:26
1:32:26
![Paзpушитeль миpoв | Worldbreaker (2025)]() 1:34:45
1:34:45
![Джей Келли | Jay Kelly (2025)]() 2:13:54
2:13:54
![Только во сне | In Your Dreams (2025)]() 1:31:16
1:31:16
![Стив | Steve (2025)]() 1:33:34
1:33:34
![Вдохновитель | The Mastermind (2025)]() 1:50:21
1:50:21
![Девушка из каюты №10 | The Woman in Cabin 10 (2025)]() 1:35:11
1:35:11
![Сны поездов | Train Dreams (2025)]() 1:43:45
1:43:45
![Баллада о маленьком игроке | Ballad of a Small Player (2025)]() 1:42:60
1:42:60
![Кей-поп-охотницы на демонов | KPop Demon Hunters (2025)]() 1:39:41
1:39:41
![Енотки]() 7:04
7:04
![Полли Покет Сезон 1]() 21:30
21:30
![Лудлвилль]() 7:09
7:09
![Простоквашино. Финансовая грамотность]() 3:27
3:27
![Тодли Великолепный!]() 3:15
3:15
![МиниФорс]() 0:00
0:00
![Панда и петушок Лука]() 12:12
12:12
![Зебра в клеточку]() 6:30
6:30
![Пластилинки]() 25:31
25:31
![Сборники «Ну, погоди!»]() 1:10:01
1:10:01
![Котёнок Шмяк]() 11:04
11:04
![Врумиз. 1 сезон]() 13:10
13:10
![Кадеты Баданаму Сезон 1]() 11:50
11:50
![Забавные медвежата]() 13:00
13:00
![Чуч-Мяуч]() 7:04
7:04
![Приключения Тайо]() 12:50
12:50
![Сандра - сказочный детектив Сезон 1]() 13:52
13:52
![Супер Зак]() 11:38
11:38
![Игрушечный полицейский Сезон 1]() 7:19
7:19
![Мартышкины]() 7:09
7:09

 1:23:45
1:23:45Скачать Видео с Рутуба / RuTube
| 256x144 | ||
| 424x240 | ||
| 640x360 | ||
| 848x480 | ||
| 1280x720 | ||
| 1920x1080 |
 3:12
3:12
2025-12-13 12:26
 6:09
6:09
2025-12-11 10:43
 6:27
6:27
2025-12-11 10:36
 2:29
2:29
2025-12-20 15:12
 3:04
3:04
2025-12-19 10:19
 3:36
3:36
2025-12-11 10:29
 3:22
3:22
2025-12-19 10:05
 4:45
4:45
2025-12-19 10:39
 3:05
3:05
2025-12-11 10:40
 2:59
2:59
2025-12-12 17:38
 3:45
3:45
2025-12-16 13:34
 4:10
4:10
2025-12-13 11:55
 2:52
2:52
2025-12-11 01:49
 2:53
2:53
2025-12-17 16:05
 2:55
2:55
2025-12-18 12:19
 2:53
2:53
2025-12-17 16:29
 2:31
2:31
2025-12-18 11:47
 4:25
4:25
2025-12-20 15:38
 2:50
2:50
2025-12-16 13:21
 2:13
2:13
2025-12-19 10:15
0/0
 1:46:56
1:46:56
2025-12-12 13:56
 1:25:31
1:25:31
2025-11-10 21:11
 1:55:53
1:55:53
2025-12-17 23:52
 1:55:08
1:55:08
2025-10-29 16:30
 1:42:50
1:42:50
2025-10-21 16:19
 1:46:40
1:46:40
2025-10-07 09:27
 2:36:13
2:36:13
2025-10-07 09:27
 1:44:57
1:44:57
2025-10-29 16:30
 1:24:45
1:24:45
2025-11-13 23:26
 1:47:25
1:47:25
2025-11-27 03:58
 1:32:26
1:32:26
2025-12-04 12:35
 1:34:45
1:34:45
2025-11-27 19:40
 2:13:54
2:13:54
2025-12-08 13:26
 1:31:16
1:31:16
2025-11-21 20:18
 1:33:34
1:33:34
2025-10-08 12:27
 1:50:21
1:50:21
2025-12-17 00:55
 1:35:11
1:35:11
2025-10-13 12:06
 1:43:45
1:43:45
2025-11-26 14:01
 1:42:60
1:42:60
2025-10-31 10:53
 1:39:41
1:39:41
2025-10-29 16:30
0/0
 7:04
7:04
2022-03-29 18:22
2021-09-22 23:09
 7:09
7:09
2023-07-06 19:20
 3:27
3:27
2024-12-07 11:00
 3:15
3:15
2025-06-10 13:56
 0:00
0:00
2025-12-22 11:53
 12:12
12:12
2024-11-29 14:21
 6:30
6:30
2022-03-31 13:09
 25:31
25:31
2022-04-01 14:30
 1:10:01
1:10:01
2025-07-25 20:16
 11:04
11:04
2023-05-18 16:41
2021-09-24 16:00
2021-09-22 21:17
 13:00
13:00
2024-12-02 13:15
 7:04
7:04
2022-03-29 15:20
 12:50
12:50
2024-12-17 13:25
2021-09-22 20:39
2021-09-22 22:07
2021-09-22 21:03
 7:09
7:09
2025-04-01 16:06
0/0

